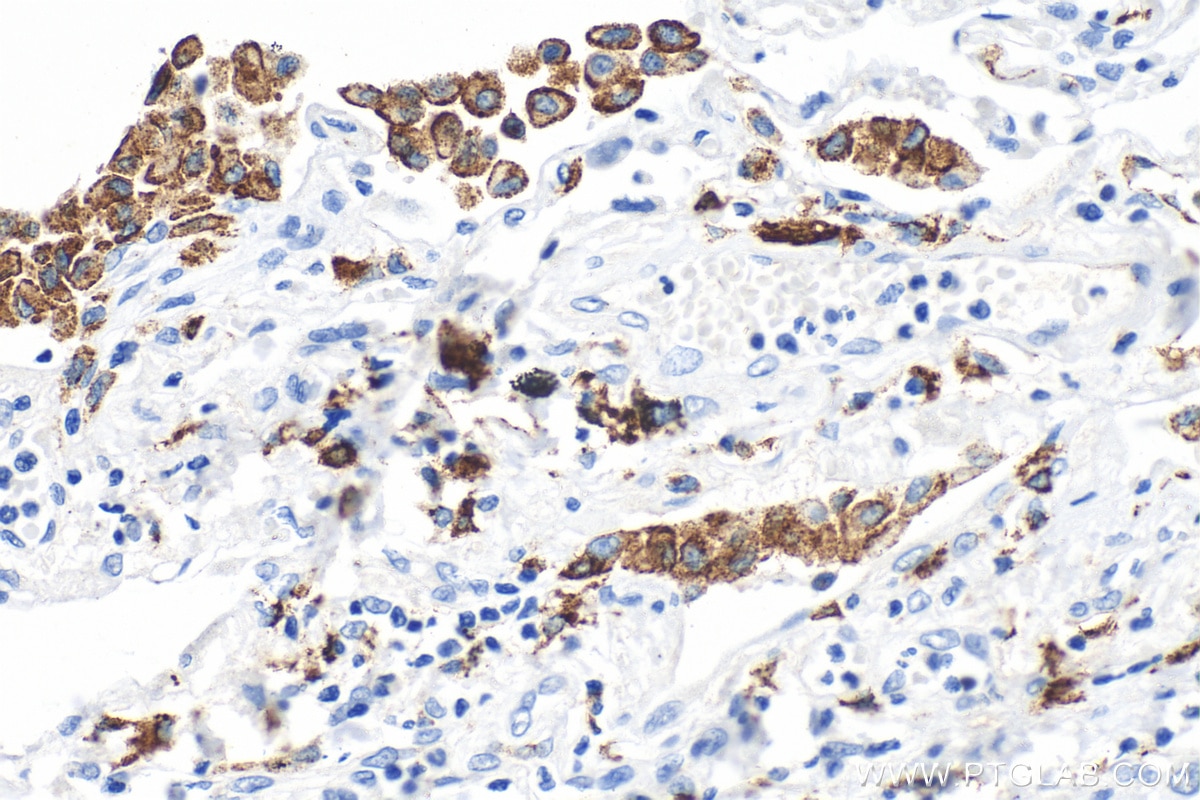

Tested Applications
| Positive WB detected in | pig liver tissue, rat liver tissue, human placenta tissue |
| Positive IHC detected in | human lung cancer tissue, human colon cancer tissue, human liver tissue, human lung tissue, human lymphoma tissue, human placenta tissue Note: suggested antigen retrieval with TE buffer pH 9.0; (*) Alternatively, antigen retrieval may be performed with citrate buffer pH 6.0 |
| Positive IF-P detected in | human placenta tissue |
Recommended dilution
| Application | Dilution |
|---|---|
| Western Blot (WB) | WB : 1:5000-1:50000 |
| Immunohistochemistry (IHC) | IHC : 1:1000-1:4000 |
| Immunofluorescence (IF)-P | IF-P : 1:50-1:500 |
| It is recommended that this reagent should be titrated in each testing system to obtain optimal results. | |
| Sample-dependent, Check data in validation data gallery. | |
Published Applications
| WB | See 4 publications below |
| IHC | See 4 publications below |
| IF | See 11 publications below |
Product Information
81525-1-RR targets CD206 in WB, IHC, IF-P, ELISA applications and shows reactivity with human, rat, pig samples.
| Tested Reactivity | human, rat, pig |
| Cited Reactivity | human |
| Host / Isotype | Rabbit / IgG |
| Class | Recombinant |
| Type | Antibody |
| Immunogen |
Peptide Predict reactive species |
| Full Name | mannose receptor, C type 1 |
| Calculated Molecular Weight | 166 kDa |
| Observed Molecular Weight | 170 kDa |
| GenBank Accession Number | NM_002438 |
| Gene Symbol | CD206 |
| Gene ID (NCBI) | 4360 |
| RRID | AB_2935558 |
| Conjugate | Unconjugated |
| Form | Liquid |
| Purification Method | Protein A purification |
| UNIPROT ID | P22897 |
| Storage Buffer | PBS with 0.02% sodium azide and 50% glycerol, pH 7.3. |
| Storage Conditions | Store at -20°C. Stable for one year after shipment. Aliquoting is unnecessary for -20oC storage. 20ul sizes contain 0.1% BSA. |
Background Information
CD206, also named as MMR, CLEC13D and MRC1, is a type I membrane receptor that mediates the endocytosis of glycoproteins by macrophages. CD206 has been shown to bind high-mannose structures on the surface of potentially pathogenic viruses, bacteria, and fungi so that they can be neutralized by phagocytic engulfment. CD206 is a 170 kDa transmembrane protein which contains 5 domains: an amino-terminal cysteine-rich region, a fibronectin type II repeat, a series of eight tandem lectin-like carbohydrate recognition domains (responsible for the recognition of mannose and fucose), a transmembrane domain, and an intracellular carboxy-terminal tail. It is expressed on most tissue macrophages, in vitro derived dendritic cells, lymphatic and sinusoidal endothelia.
Protocols
| Product Specific Protocols | |
|---|---|
| IF protocol for CD206 antibody 81525-1-RR | Download protocol |
| IHC protocol for CD206 antibody 81525-1-RR | Download protocol |
| WB protocol for CD206 antibody 81525-1-RR | Download protocol |
| Standard Protocols | |
|---|---|
| Click here to view our Standard Protocols |
Publications
| Species | Application | Title |
|---|---|---|
ACS Appl Mater Interfaces Hydrogel Loaded with Peptide-Containing Nanocomplexes: Symphonic Cooperation of Photothermal Antimicrobial Nanoparticles and Prohealing Peptides for the Treatment of Infected Wounds | ||
Cell Death Discov SPON2 facilitates osteosarcoma development by inducing M2 macrophage polarization through activation of the NF-κB/VEGF signaling axis | ||
Comput Struct Biotechnol J Integrating single-cell sequencing and clinical insights to explore malignant transformation in odontogenic keratocyst | ||
Sci Rep Programmed cell death-related gene IL20RA facilitates tumor progression and remodels tumor microenvironment in thyroid cancer | ||
BMC Complement Med Ther Qingrehuoxue formula enhances anti-PD-1 immunotherapy in NSCLC by remodeling the tumor immune microenvironment via TREM2 signaling | ||
Life Sci Lack of ALCAT1 enhances the protective effects of aerobic exercise on kidney in HFpEF mice |
Reviews
The reviews below have been submitted by verified Proteintech customers who received an incentive for providing their feedback.
FH Kenzo (Verified Customer) (08-15-2023) | I highly recommend this antibody as it performs best among CD206 antibodies that we have tested. I was able to detect very robust immunofluorescent signals with this antibody from a subset of macrophages in mouse nerve tissues.
|